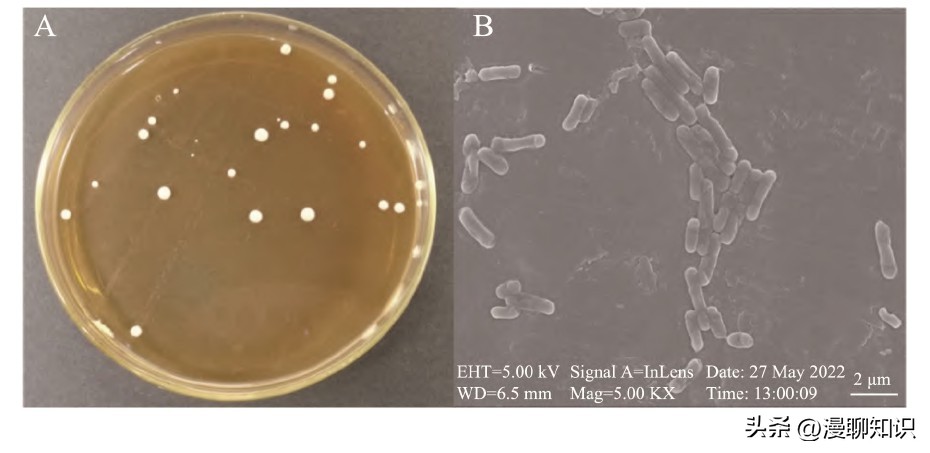
抑制幽门螺旋杆菌的乳酸菌,抑制幽门螺杆菌的乳酸菌
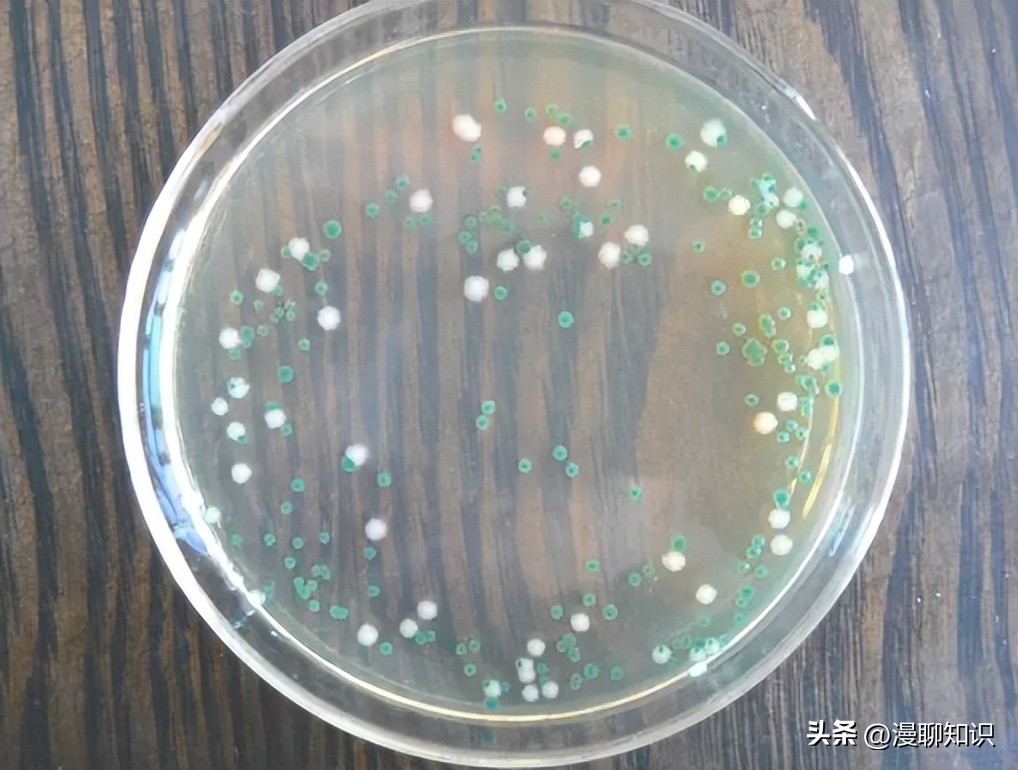
抑制幽门螺旋杆菌的乳酸菌,抑制幽门螺杆菌的乳酸菌
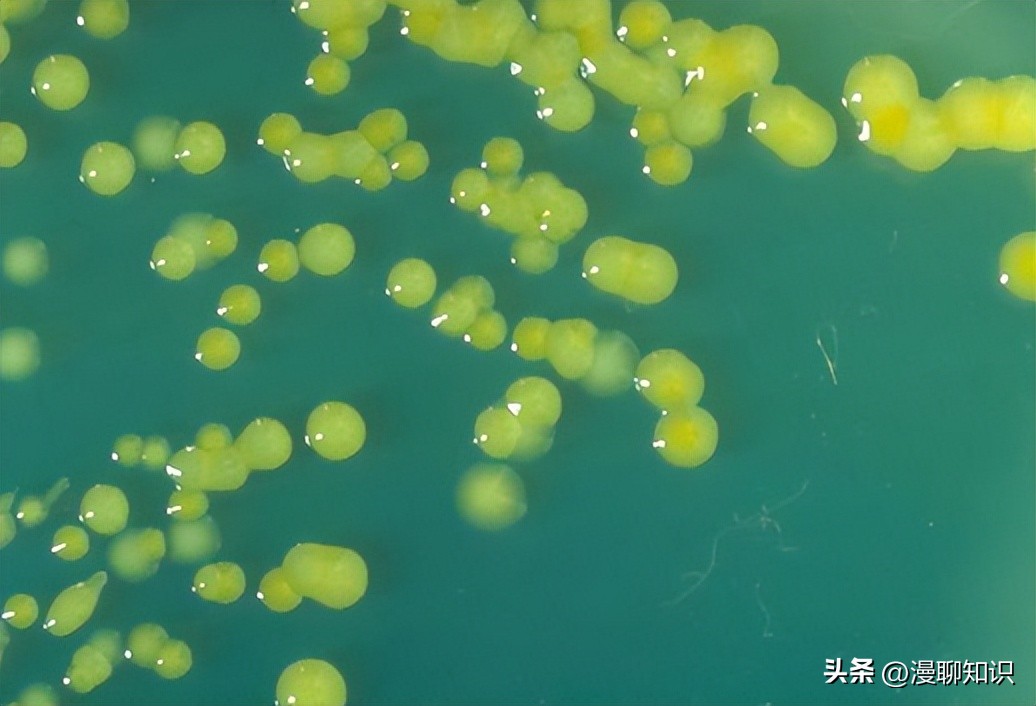
抑制幽门螺旋杆菌的乳酸菌,抑制幽门螺杆菌的乳酸菌

在阅读此文前,诚邀您请点点右上方的“关注”,既方便您进行讨论与分享,还能及时阅读最新内容,感谢您的支持。
结果与分析
乳酸菌菌株分离和对E.sakazakii的抑菌初筛
从大弹涂鱼肠道样品中分离出11株有钙溶圈的菌种,从酸菜样品中初筛分离10株有钙溶圈的菌种,排除多重影响之后,有一株命名为SA3的菌株对E.sakazakii的抑菌效果较好,抑菌直径明显大于其他菌株。
菌株SA3与SA8之间CFS的抑菌效果不显著,P为0.012>0.05,SA3上清液与其他菌株相比抑菌效果显著(P<0.05)。
而SA3经排除过氧化氢后抑菌圈直径与其他菌株抑菌效果最佳。
对乳酸菌的抑菌效果进行综合评价筛选,认为菌株SA3经排除过氧化氢后抑菌效果最佳,故将后续实验菌株选为SA3。
表1 抑菌优势菌株对阪崎肠杆菌的抑制作用

注:牛津杯直径:7.8 mm,上样:200μL。
乳酸菌菌株的鉴定
形态学鉴定
在MRS固体培养基上划线分离SA3菌株,于37℃培养箱内培养48 h。
观察培养基表面的乳酸菌形态,菌落颜色呈白色,形状成圆形,边缘整齐,凸起,菌落直径在1~5 mm范围内。
在扫描电子显微镜下观察菌体形态,观察发现菌体呈短杆状,单个菌体长度为2μm左右。
革兰氏染色镜检结果显示蓝紫色,为革兰氏阳性菌。
图1 菌株SA3的MRS固体培养基生长形态图(A)与扫描电镜图(B)
菌株SA3的生理生化鉴定
依照《常见细菌系统鉴定手册》初步判断SA3菌株为乳酸菌。
分子生物学鉴定
琼脂糖电泳结果所示,菌株SA3经过PCR扩增后的各样品条带大小均在1500 bp左右,与预期大小相符。
系统发育树构建
采用MEGA 6.0软件构建系统发育树。
菌株SA3与Limosilactobacillus fermentum相似性99.18%,中文名为发酵黏液乳杆菌。
表明菌株SA3在亲缘关系上与发酵黏液乳杆菌(L.fermentum)最为相近。
因此通过菌落形态及16S r DNA序列分析,将菌株SA3鉴定为L.fermentum,获得Gene Bank数据库序列登录号MT463656.1。

注:+表示结果呈阳性;-表示结果呈阴性。

图2 菌株SA3 16S r DNA的PCR产物电泳图

图3 发酵黏液乳杆菌SA3系统发育进化树
发酵黏液乳杆菌SA3的生物学特性
发酵黏液乳杆菌SA3的生长曲线及抑菌物质产生曲线
细菌素的产生与其菌株生长具有一定的关联,研究表明一般在对数生长期产生细菌素。
从OD600 nm可以看出发酵黏液乳杆菌SA3在0~4 h变化较少,图中基本保持直线,代表菌体生长缓慢,从8 h开始迅速生长,20 h后趋于平稳生长至1.5左右达到稳定。
发酵黏液乳杆菌SA3在37℃培养4 h后,随着菌株生长,p H开始显著下降,8 h达到5.8左右,到12 h后趋于稳定,但仍有缓慢下降趋势,发酵液最终p H维持在4.2左右。
在培养0~12 h内菌体迅速生长,繁殖旺盛,菌体数量急剧增多,产生大量代谢产物有机酸,从而导致p H大量下降。
发酵黏液乳杆菌SA3的发酵上清液在0~12 h内无抑菌活性,16 h后开始产生大量抑菌活性物质,直到对数生长期末36 h达到16.84 mm的峰值。
抑菌活性随着菌株的繁殖而逐渐增强,但是36 h之后抑菌活性有所下降,28 h后发酵液p H基本保持稳定,而抑菌圈直径仍在增加,这表明SA3除了产酸之外,还可以产生其他抑菌物质。

图4 发酵黏液乳杆菌SA3的生长曲线、p H变化曲线及抑菌物质的产生曲线
发酵黏液乳杆菌SA3发酵液的杀菌时间曲线
由实验可以看出,发酵黏液乳杆菌SA3发酵上清液在10 min时即能明显杀灭阪崎肠杆菌。
根据营养琼脂培养基上的生长结果来看,杀灭率达到99.99%以上所需要的时间为60 min。
这表明发酵黏液乳杆菌中的抗菌物质对阪崎肠杆菌的杀灭速度较快。

乳酸菌上清液的特性测定
发酵黏液乳杆菌SA3发酵液的蛋白酶稳定性
发酵黏液乳杆菌SA3产生的抗菌物质可以被蛋白酶K、胰蛋白酶、α-凝乳蛋白酶水解,但仍有抑菌效果,说明发酵黏液乳杆菌SA3发酵液中产生的抗菌物质为蛋白类。
由实验可以看出,单独使用蛋白酶时,此时的酶的浓度达不到对阪崎肠杆菌产生抑制作用的浓度。
而CFS经过蛋白酶K、α-凝乳蛋白酶和胰蛋白酶处理之后对指示菌的抑菌率分别下降了18.6%、13.85%、18.07%,且CFS与处理组数据之间有显著性差异(P<0.05),表明蛋白酶将发酵上清液中的抗菌物质酶解一部分。
说明抗菌物质含有蛋白类物质或肽类抗菌物质,并且可能存在其他抗菌物质如胞外多糖等。

图5 菌株SA3发酵液的杀菌时间曲线

注:与模型组比较,*表示差异显著(P<0.05),**表示差异极显著(P<0.01)。
发酵黏液乳杆菌SA3抗菌物质的热稳定性
将发酵黏液乳杆菌SA3的上清液分别置于不同条件下热处理20 min,冷却至室温,以未经热处理的发酵液作为对照进行抑菌实验。
当处理温度为80℃与121℃时具有显著差异性。
当浓缩液经过高压灭菌锅121℃处理20 min后,抑菌直径为12.12 mm,对比未经处理的发酵液16.56 mm,组间有显著性差异,抑菌能力有所下降,说明121℃的灭菌高温会杀灭发酵上清液中的一部分抑菌活性物质,可能是抑菌肽类物质失活,导致抑菌能力降低。
综上,发酵黏液乳杆菌抗菌物质具有良好的热稳定性,对后续食品添加剂研究开发具有参考作用。
同时,大量研究也证明了乳酸菌细菌素具有良好的热稳定性,可以在100℃甚至121℃高温条件下保持稳定。

图6 不同温度下发酵黏液乳杆菌SA3产细菌素对E.sakazakii抑菌效果
发酵黏液乳杆菌SA3抑菌谱的测定结果
由实验可知发酵黏液乳杆菌SA3所产的抗菌物质对所选指示菌均显示了较强的抑菌活性,其中对鼠伤寒沙门氏菌Salmonella typhimurium、金黄色葡萄球菌Staphylococcus aureus、白色念珠菌Monilia albican这3种指示菌显示了强效抑菌活性,抑菌圈直径达到16 mm以上。
对其他的指示菌大肠埃希氏菌Escherichia coli、单核细胞李斯特氏菌Listeria monocytogenes、蜡样芽孢杆菌Bacillus cereus均显示了较强的抑菌活性,抑菌圈直径为13~16 mm。
综上,发酵黏液乳杆菌SA3所产的抗菌物质对食品常见的革兰氏阳性菌、革兰氏阴性和真菌均有良好的抑制作用。

注:+++:抑菌圈直径16.0~20.0 mm;++:抑菌圈直径13.0~16.0 mm;+:抑菌圈直径8.0~13.0 mm。
发酵黏液乳杆菌SA3粗提抑菌物质的分离纯化
采用有机试剂萃取法,乙酸乙酯的萃取效果最佳。
以乙酸乙酯粗提取发酵黏液乳杆菌SA3的抑菌物质。
其中实验中乙酸乙酯对阪崎肠杆菌无抑菌圈的产生,乙酸乙酯对阪崎肠杆菌无抑菌效果。
100μg/m L的抑菌物质对1.5×108 CFU/m L的阪崎肠杆菌抑菌圈直径为(19.52±0.23) mm,证明细菌素提取成功。


图7 乙酸乙酯的抑菌效果及乙酸乙酯粗提抗菌物质的抑菌效果
发酵黏液乳杆菌SA3的抑菌机制初探
观测扫描电镜下乙酸乙酯粗提抗菌物质处理后阪崎肠杆菌的形态变化。
扫描电镜结果显示,未处理的阪崎肠杆菌菌体光滑圆润,而经过发酵黏液乳杆菌SA3粗提细菌素处理过的菌体干瘪皱缩,并且失水畸形,结果表明菌株所产抗菌物质通过破坏了病原菌的细胞壁,导致病原菌死亡。

图8 扫描电镜下阪崎肠杆菌形态变化
注:A:未经处理的阪崎肠杆菌;B:阪崎肠杆菌经发酵黏液乳杆菌SA3粗提细菌素处理。
透射电镜结果所示,未经细菌素处理得的阪崎肠杆菌细胞形态完整无缺损,细胞壁结构紧实光滑完整,胞内物质排列正常有序。
细胞壁与细胞膜紧密贴合以保持阪崎肠杆菌的细胞外形及防止被渗透损伤。
而经发酵黏液乳杆菌SA3细菌素处理后的阪崎肠杆菌所示,阪崎肠杆菌细胞质等内容物散乱,发生外泄现象。
细胞壁边缘破损,轮廓模糊不规则,并出现空腔现象。
说明发酵黏液乳杆菌SA3细菌素作用于阪崎肠杆菌细胞壁,破坏阪崎肠杆菌细胞壁致使菌体死亡。

图9 透射电镜下阪崎肠杆菌形态变化
益生菌的抑菌原理主要是代谢产物破坏致病菌的细胞膜或胞内结构[30],植物乳杆菌通过改变致病菌细胞壁的通透性,影响蛋白质和核酸的正常表达,可以产生细菌素、苯乳酸等抗菌物质,从而起到抑菌作用。
鼠李糖乳杆菌所产细菌素除了影响蛋白质和核酸的正常表达,还可在细菌的表面形成孔洞从而发挥抑菌作用。
本研究通过扫描电镜及透射电镜观察细菌素作用于阪崎肠杆菌的细胞壁,通过破坏其细胞壁使得阪崎肠杆菌细胞质等内容物散乱,发生外泄现象,达到抑制阪崎肠杆菌的作用。
本研究采用琼脂平板扩散法,从酸菜、大弹涂鱼肠道中分离出有较好抑菌效果的菌株SA3,其发酵液对阪崎肠杆菌具有较好的抑菌效果,对其他致病菌革兰氏阳性菌和革兰氏阴性菌显示了很好的抑制作用,具有一定的广谱性。
经生理生化实验和分子生物学鉴定认定为发酵黏液乳杆菌。
经蛋白酶稳定性实验及热稳定性实验推断抗菌物质含有蛋白类或肽类抑菌物质。
以乙酸乙酯提取抑菌物质,通过对提取物处理过的阪崎肠杆菌扫描电镜及透射电镜观察,发现抑菌物质作用于阪崎肠杆菌细胞壁,可破坏细胞内容物。
本研究分离到的发酵黏液乳杆菌有望应用于乳制品中阪崎肠杆菌的生物防腐。
高鹏等从酸菜中分离出植物乳杆菌HLJ-174的抗菌产物可以抑制大肠杆菌、荧光假单胞菌等多种革兰氏阳性菌和革兰氏阴性菌以及串珠镰刀菌等真菌的生长,属于广谱的细菌素。
新发现的细菌素Ent35-Mcc V对革兰氏阳性和革兰氏阴性致病菌有抗菌活性。
而本研究中发酵黏液乳杆菌SA3所产生的抗菌物质对多种革兰氏阳性菌和革兰氏阴性菌有抑制作用,如阪崎肠杆菌、鼠伤寒沙门氏菌、金黄色葡萄球菌、大肠埃希氏菌、单核细胞李斯特氏菌和蜡样芽孢杆菌等,同时对白色念珠菌真菌的生长也有抑制作用,说明菌株发酵液的抗菌物质具有一定的广谱抑菌作用。

发酵黏液乳杆菌属于乳杆菌科中的乳杆菌属,广泛分布于植物和胃肠道中[38]。
发酵黏液乳杆菌本身多用于谷类食品的发酵和生产,如发酵食品(如面包、酸奶、泡菜等)的制备。
而发酵粘液乳杆菌的细菌素具有一定抑菌效果。
DAVODADI等从健康婴儿粪便中获得4株发酵黏液乳杆菌,所产细菌素可抑制志贺氏菌、肠炎沙门氏菌、小肠结肠炎耶尔森氏菌等肠道致病菌的生长。
GU等编码发酵黏液乳杆菌细菌素基因后,产生的细菌素对金黄色葡萄球菌、大肠杆菌、多种革兰氏阴性菌和阳性菌均有良好抑制作用。
但应用发酵黏液乳杆菌细菌素抑制阪崎肠杆菌方面的研究仍处于起步阶段,相关抑菌的研究仍在探究中。

杜琨研究表明大部分乳酸菌细菌素具有热稳定性,溶易于水,不受紫外线等的影响。
并且乳酸菌细菌素对人体无害;且产细菌素的菌株自身具有免疫力。
未来乳酸菌多肽药剂、乳酸菌细菌素防腐剂、乳酸菌饲料等产品具有广阔的市场应用前景。
本研究中发酵黏液乳杆菌SA3抑菌物质具有很好的耐热性,可适用于需要高温加工的食品中,拓宽了其应用范围。
此外SA3抑菌物质具有蛋白酶敏感性,使其进入人体内能被各种蛋白酶分解,不会对身体产生危害。
发酵黏液乳杆菌SA3产生的抑菌物质包括有机酸、过氧化氢、细菌素等,具有较好的基础应用于食品保鲜食品加工中。
综上所述,本研究分离所得的发酵黏液乳杆菌SA3所产细菌素对阪崎肠杆菌的抑菌效果显著,但仍需后续实验继续探究抑菌粗提物的结构及抑菌机制,为其作为天然抑菌剂在食品中发挥作用提供理论依据。
LI H,FENG XY,ZENG XX,et al.Preparation of silver nanoparticles/polymethylmethacrylate/cellulose acetate film and its inhibitory effect on Cronobacter sakazakii in infant formula milk[J].J Dairy Sci,2023,1(106):84-95.
DRUDY D,MULLANE NR,QUINN T,et al.Enterobacter sakazakii:An emerging pathogen in powdered infant formula[J].Food Saf,2006,(42):996-1002.
LING N,FOESYTHE S,WU Q,et al.Insights into Cronobacter sakazakii biofilm formation and control strategies in the food industry[J].Engineering,2020,6(4):393-405.